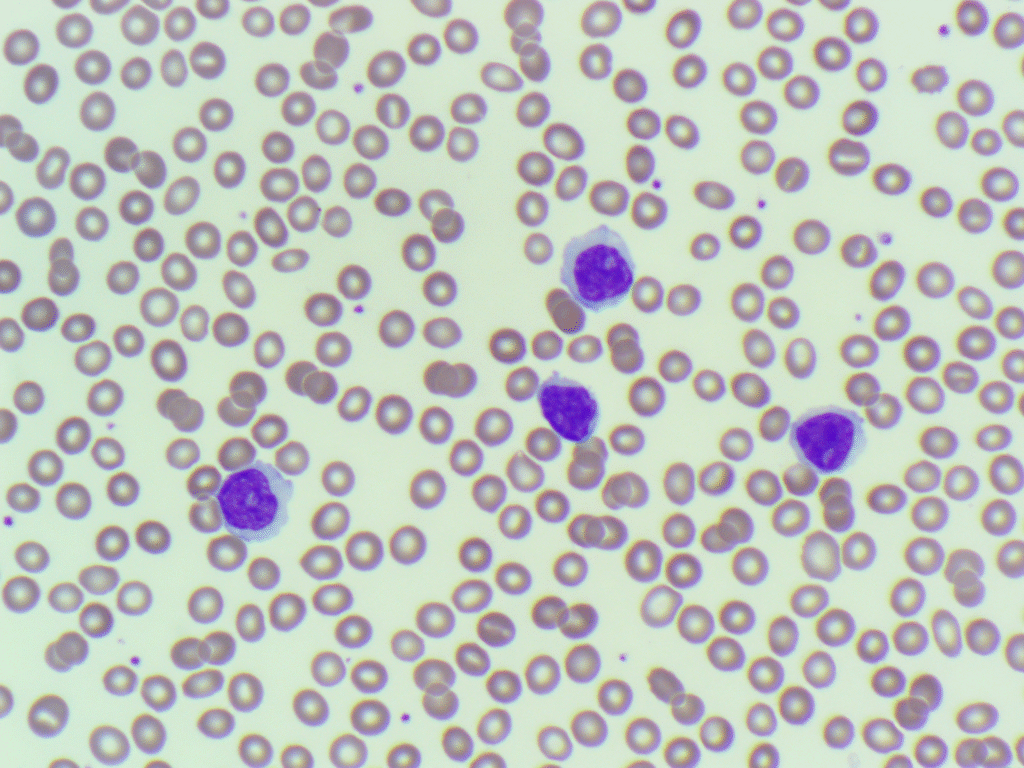
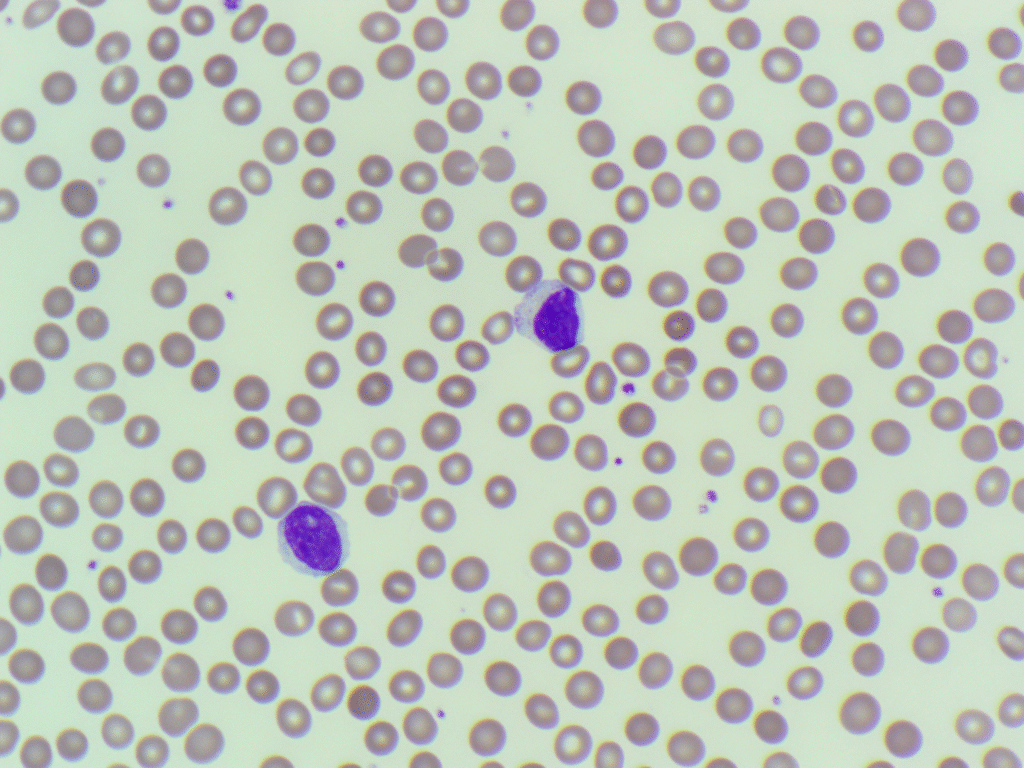
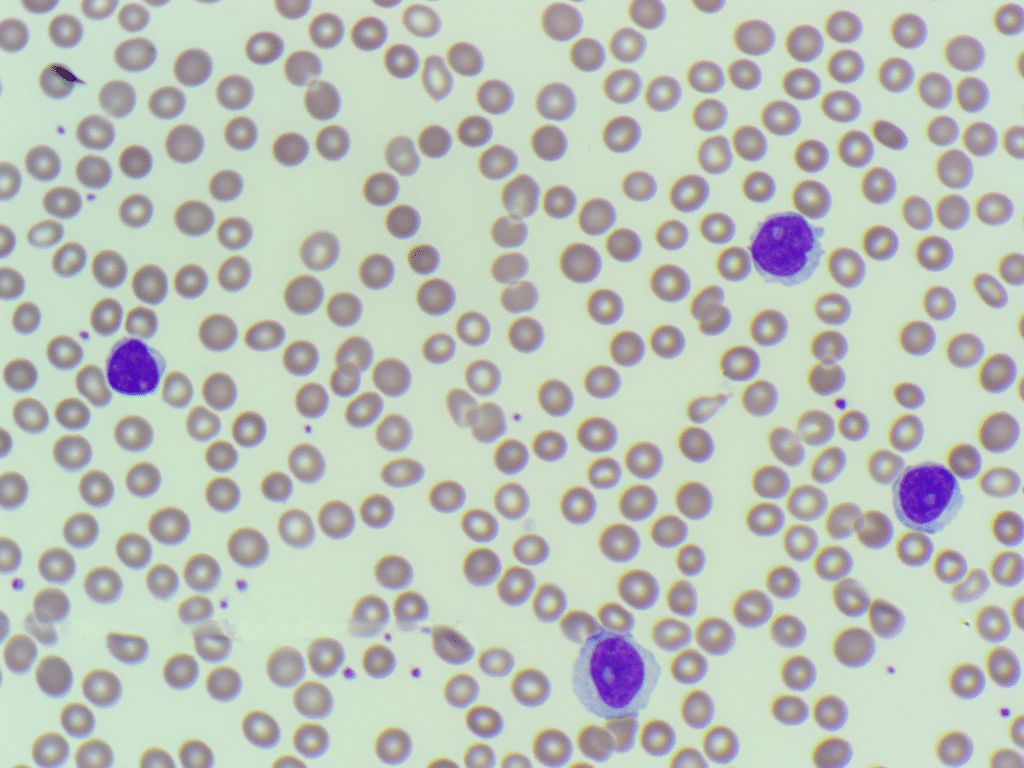

Thank you to everyone who participated in the first case of the year!
While the overnight manual differential flagged a high percentage of “blasts,” a closer look and a follow-up review confirmed these cells were actually prolymphocytes. In this case, the BMS was likely alerted by the presence of prominent nucleoli and a slightly larger cell size.

The “Prolymphocyte Trap”
- These cells had clumped “block-like” chromatin characteristic of mature B-cells, rather than the fine, lacy appearance of true myeloblasts or lymphoblasts.
- The Proportion: While the images highlighted these striking prolymphocytes, they actually represented a minority of the total lymphoid population. To be classified as Prolymphocytic Leukaemia (PLL), these cells must typically exceed 55% of the total lymphocytes. In this patient, the background was still dominated by small, mature lymphocytes of CLL.

The Sysmex WDF scattergram showed the population drifting into the “grey zone” (upwards towards the SFL axis). This occurs because prolymphocytes have a higher RNA content and a larger size than resting lymphocytes, causing increased fluorescence and side scatter that the algorithm can’t quite place.
Key Learning Points:
- Don’t let a nucleolus default you to “Blast”: Always assess the chromatin density.
- Context is King: In an older patient with a lymphocytosis, always consider a lymphoproliferative disorder before an acute leukaemia.
- Quantify: Always calculate the percentage of prolymphocytes relative to the total lymphocyte count to differentiate between CLL, CLL/PL, and B-PLL.
One Comment
Excellent educational article. There can be confusion between the cells, mantle cell lymphoma can also be problematic.